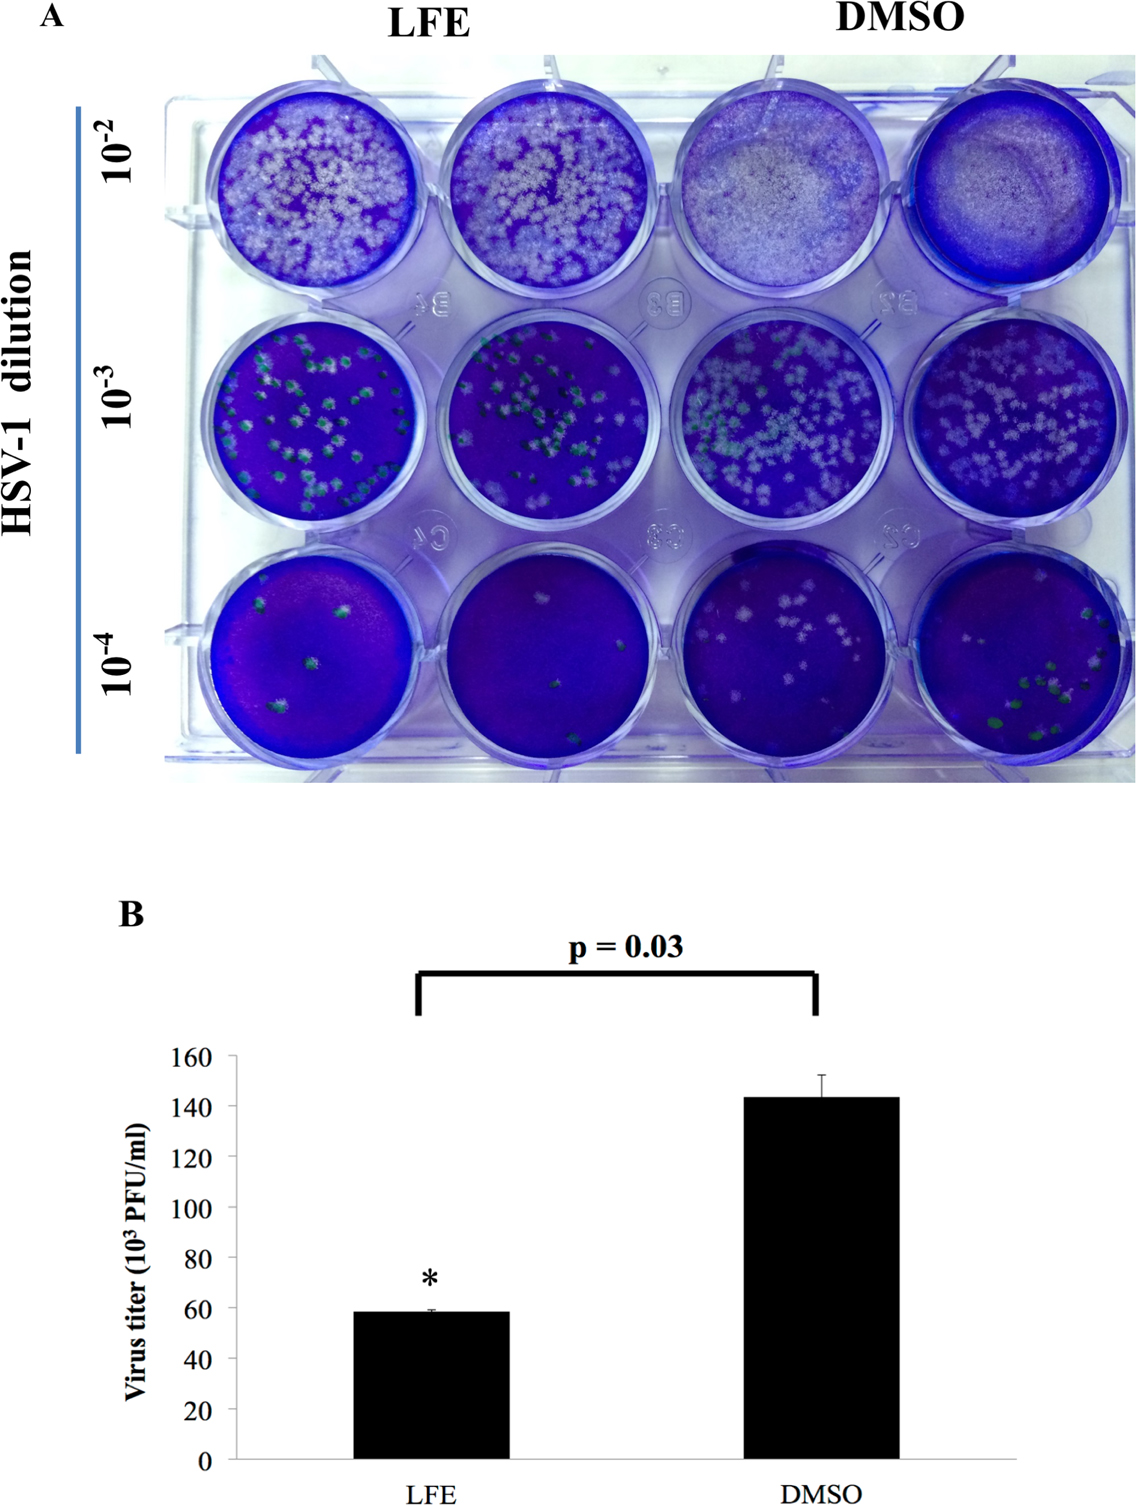

Figure 5. The inhibition of LFE on HSV-1-infected cells was evaluated with a standard plaque assay in PK-15 cells. A: The number of plaques in the Lychee flower extract (LFE) group was lower than those in the dimethyl sulfoxide (DMSO) group.
B: The titer declined in the LFE group. Bars are mean ± standard error of the mean (SEM). * p<0.05 when compared with the DMSO
group.